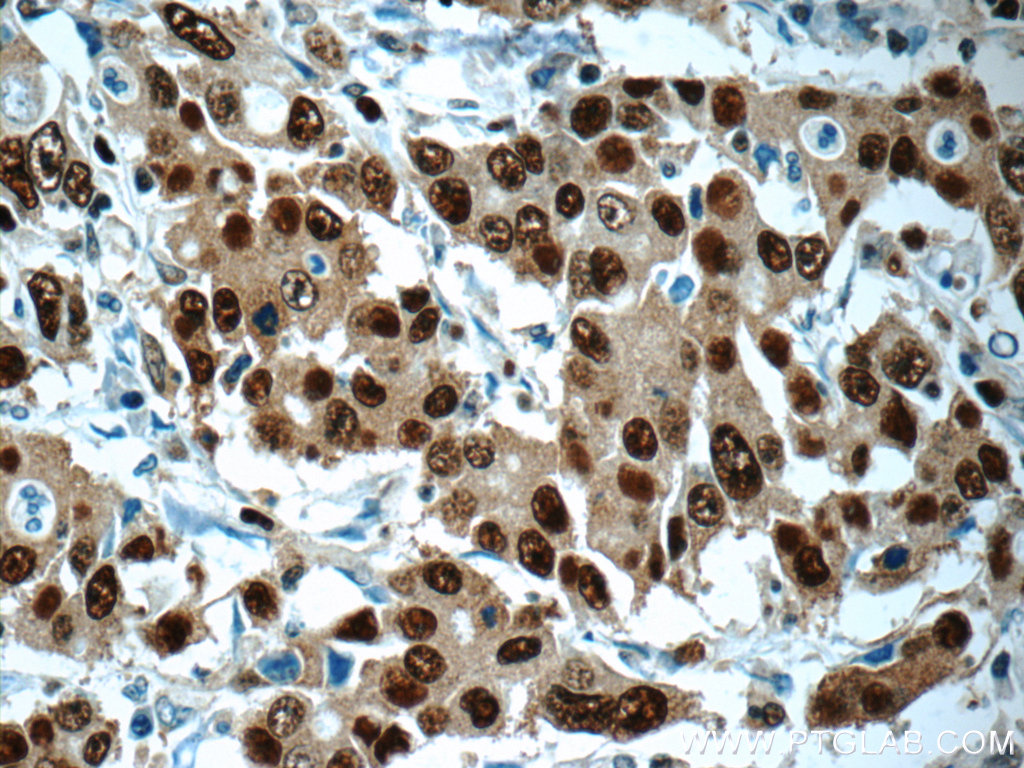

验证数据展示
经过测试的应用
| Positive WB detected in | HeLa cells, mouse testis tissue, Raji cells, HEK-293 cells, NIH/3T3 cells, MCF-7 cells, rat liver tissue, HepG2 cells, Jurkat cells |
| Positive IP detected in | HEK-293 cells |
| Positive IHC detected in | human breast cancer tissue, human gliomas tissue, human stomach cancer tissue Note: suggested antigen retrieval with TE buffer pH 9.0; (*) Alternatively, antigen retrieval may be performed with citrate buffer pH 6.0 |
| Positive IF-P detected in | human breast cancer tissue |
推荐稀释比
| 应用 | 推荐稀释比 |
|---|---|
| Western Blot (WB) | WB : 1:2000-1:14000 |
| Immunoprecipitation (IP) | IP : 0.5-4.0 ug for 1.0-3.0 mg of total protein lysate |
| Immunohistochemistry (IHC) | IHC : 1:20-1:200 |
| Immunofluorescence (IF)-P | IF-P : 1:50-1:500 |
| It is recommended that this reagent should be titrated in each testing system to obtain optimal results. | |
| Sample-dependent, Check data in validation data gallery. | |
产品信息
24036-1-AP targets PCNA in WB, IHC, IF-P, IP, RIP, ELISA applications and shows reactivity with human, mouse, rat samples.
| 经测试应用 | WB, IHC, IF-P, IP, ELISA Application Description |
| 文献引用应用 | WB, IHC, IF, RIP |
| 经测试反应性 | human, mouse, rat |
| 文献引用反应性 | human, mouse, rat, rabbit, zebrafish |
| 免疫原 |
CatNo: Ag7416 Product name: Recombinant human PCNA protein Source: e coli.-derived, PET28a Tag: 6*His Domain: 8-256 aa of BC000491 Sequence: QGSILKKVLEALKDLINEACWDISSSGVNLQSMDSSHVSLVQLTLRSEGFDTYRCDRNLAMGVNLTSMSKILKCAGNEDIITLRAEDNADTLALVFEAPNQEKVSDYEMKLMDLDVEQLGIPEQEYSCVVKMPSGEFARICRDLSHIGDAVVISCAKDGVKFSASGELGNGNIKLSQTSNVDKEEEAVTIEMNEPVQLTFALRYLNFFTKATPLSSTVTLSMSADVPLVVEYKIADMGHLKYYLAPKIE 种属同源性预测 |
| 宿主/亚型 | Rabbit / IgG |
| 抗体类别 | Polyclonal |
| 产品类型 | Antibody |
| 全称 | proliferating cell nuclear antigen |
| 别名 | Cyclin, proliferating cell nuclear antigen |
| 计算分子量 | 29 kDa/31 kDa |
| 观测分子量 | 36-38 kDa |
| GenBank蛋白编号 | BC000491 |
| 基因名称 | PCNA |
| Gene ID (NCBI) | 5111 |
| RRID | AB_2879414 |
| 偶联类型 | Unconjugated |
| 形式 | Liquid |
| 纯化方式 | Antigen affinity purification |
| UNIPROT ID | P12004 |
| 储存缓冲液 | PBS with 0.02% sodium azide and 50% glycerol, pH 7.3. |
| 储存条件 | Store at -20°C. Stable for one year after shipment. Aliquoting is unnecessary for -20oC storage. |
背景介绍
The proliferating cell nuclear antigen (PCNA), a protein synthesized in early G1 and S phases of the cell cycle, functions in cell cycle progression, DNA replication and DNA repair. In early S phase, PCNA exhibits granular distribution and is absent from the nucleoli; however, in late S phase, it relocates to the nucleoli. PCNA exists in two basic forms: one involved in ongoing DNA replication, which localizes specifically to the nucleus, and a second, soluble form, not implicated in constant synthesis. Interestingly, the latter form degrades in the presence of organic solvents, rendering it undetectable by histological methods in tissues using organic fixatives, and thus also providing a method of visualizing only the synthesizing form.This antibody specifically react with the 36kd human PCNA protein.
实验方案
| Product Specific Protocols | |
|---|---|
| IF protocol for PCNA antibody 24036-1-AP | Download protocol |
| IHC protocol for PCNA antibody 24036-1-AP | Download protocol |
| IP protocol for PCNA antibody 24036-1-AP | Download protocol |
| WB protocol for PCNA antibody 24036-1-AP | Download protocol |
| Standard Protocols | |
|---|---|
| Click here to view our Standard Protocols |
发表文章
| Species | Application | Title |
|---|---|---|
Int J Biol Sci Tendon Cells Root Into (Instead of Attach to) Humeral Bone Head via Fibrocartilage-Enthesis | ||
Biochem Pharmacol Plasma Exosomes Confer Hypoxic Pulmonary Hypertension by Transferring LOX-1 Cargo to Trigger Phenotypic Switching of Pulmonary Artery Smooth Muscle Cells | ||
Biochem Pharmacol CGRP attenuates pulmonary vascular remodeling by inhibiting the cGAS-STING-NFκB pathway in pulmonary arterial hypertension | ||
Am J Cancer Res YY1-induced lncRNA00511 promotes melanoma progression via the miR-150-5p/ADAM19 axis | ||
Hepatol Commun Hepatocellular carcinoma cells downregulate NADH:Ubiquinone Oxidoreductase Subunit B3 to maintain reactive oxygen species homeostasis |